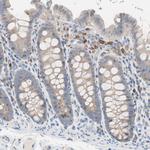
CLEC4D Antibody in Immunohistochemistry (Paraffin) (IHC (P))

Search
Invitrogen
CLEC4D Polyclonal Antibody
{{$productOrderCtrl.translations['antibody.pdp.commerceCard.promotion.promotions']}}
{{$productOrderCtrl.translations['antibody.pdp.commerceCard.promotion.viewpromo']}}
{{$productOrderCtrl.translations['antibody.pdp.commerceCard.promotion.promocode']}}: {{promo.promoCode}} {{promo.promoTitle}} {{promo.promoDescription}}. {{$productOrderCtrl.translations['antibody.pdp.commerceCard.promotion.learnmore']}}
产品信息
PA5-52131
种属反应
宿主/亚型
分类
类型
抗原
偶联物
形式
浓度
规格
纯化类型
保存液
内含物
保存条件
运输条件
RRID
产品详细信息
Immunogen sequence: KLEHHAKLKC IKEKSELKSA EGSTWNCCPI DWRAFQSNCY FPLTDNKTWA ESERNCSGMG AHLMTISTEA EQNFIIQFLD RRLSYFLGLR DENAKGQWRW VDQTPFNPRR
Highest antigen sequence identity to the following orthologs: Mouse - 65%, Rat - 62%.
靶标信息
This gene encodes a member of the C-type lectin/C-type lectin-like domain (CTL/CTLD) superfamily. Members of this family share a common protein fold and have diverse functions, such as cell adhesion, cell-cell signalling, glycoprotein turnover, and roles in inflammation and immune response. This gene is closely linked to other CTL/CTLD superfamily members on chromosome 12p13 in the natural killer gene complex region.
仅用于科研。不用于诊断过程。未经明确授权不得转售。
篇参考文献 (0)
生物信息学
蛋白别名: C-type (calcium dependent, carbohydrate-recognition domain) lectin, superfamily member 8; C-type lectin domain family 4 member D; C-type lectin receptor; C-type lectin superfamily member 8; C-type lectin-like receptor 6; CD368; CLEC-6; CLECSF8Mpcl; DC-associated C-type lectin 3; Dectin 3; Dendritic cell-associated C-type lectin 3; macrophage C-type lectin; membrane receptor; MGC40078; superfamilymember 8
基因别名: CD368; CLEC-6; CLEC4D; CLEC6; CLECSF8; Dectin-3; MCL; MPCL
UniProt ID: (Human) Q8WXI8
Entrez Gene ID: (Human) 338339